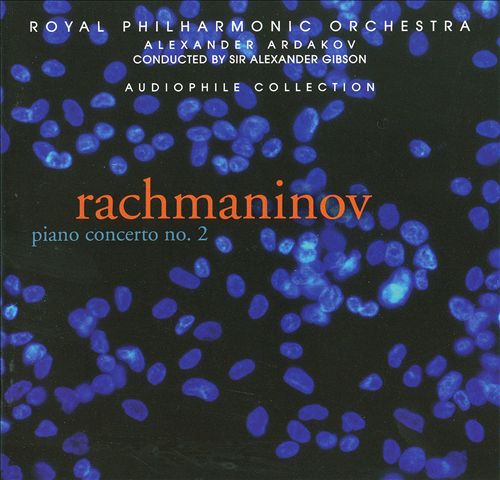

Alexander Gibson (알렉산더 깁슨)
100
10,000
1,400
ARTIST INFO
From WIKIPEDIA KOREA
RELEASED ALBUMS
-
Rachmaninov: Piano Concerto No. 2January 10, 2012
-
Berlioz: OverturesOctober 11, 2011
-
Paganini: Violin Concertos Nos. 1 & 4June 28, 2011
-
Sibelius: Symphony No. 2; Karelia SuiteJune 14, 2011
-
Sibelius: Symphony No. 1; Karelia Suite; Swan of Tuonela; FinlandiaJuly 13, 2010
-
Berlioz: Symphonie FantastiqueJanuary 26, 2010
-
Rachmaninov: Symphony No. 2October 30, 2008
-
Puccini: ToscaFebruary 27, 2007
-
Puccini: ToscaJanuary 30, 2007
-
Sibelius: Orchestral Music & Songs, etcNovember 28, 2005
-
Handel: Music for the Royal Fireworks; 6 Overtures & Sinfonias; Oboe Concerto No. 3September 6, 2005
-
Sibelius: Tone PoemsJanuary 25, 2005
-
Mozart: Sinfonia Concertante; ConcertoneMay 20, 2003
-
Fricker, Orr, Simpson: SymphoniesMarch 4, 2003
-
Elgar: OverturesAugust 27, 2002
-
Saint-Saëns: The Carnival of the AnimalsOctober 1, 2001
-
Mendelssohn: Hebrides Overture; Symphony No. 3 "Scottish"; Symphony No. 4 "Italian"October 1, 2001
-
Handel: Water MusicAugust 28, 2001
RELATED ARTISTS
-
Edward Elgar
-
Charles Mackerras
-
Gustav Holst
-
Jean Sibelius
-
William Walton
-
Edvard Grieg
-
Camille Saint-Saëns
-
Ludwig van Beethoven
-
Hector Berlioz
-
Georges Bizet
-
César Franck
-
Christoph Willibald Gluck
-
Charles Gounod
-
George Frederick Handel
-
Hamish MacCunn
-
Felix Mendelssohn
-
Wolfgang Amadeus Mozart
-
Gioachino Rossini
-
Pyotr Il'yich Tchaikovsky
-
Giuseppe Verdi
-
Edward Downes
-
Mark Elder
-
Richard Hickox
-
Henryk Szeryng
-
Teresa Berganza
-
Philip Fowke
-
Peter Katin
-
London Symphony Orchestra
-
New Philharmonia Orchestra
-
Royal Opera House Covent Garden Orchestra
-
Royal Scottish National Orchestra
-
Scottish Chamber Orchestra
-
Scottish National Orchestra
ARTIST SHOUTS